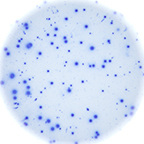
Enzymatic B cell well image

B Cell Kits
Reliable detection of rare antigen-specific T and/or B cells has been a major challenge for immune monitoring. For over two decades, CTL has been leading this field with its ImmunoSpot® platform. B Cell Kits contain capture and detection antibodies, enzymatic or fluorescent detection reagents, diluent buffers and PVDF membrane plates. Explore our catalogue of available Enzymatic and Fluorescent B Cell ImmunoSpot® kit combinations for different species.